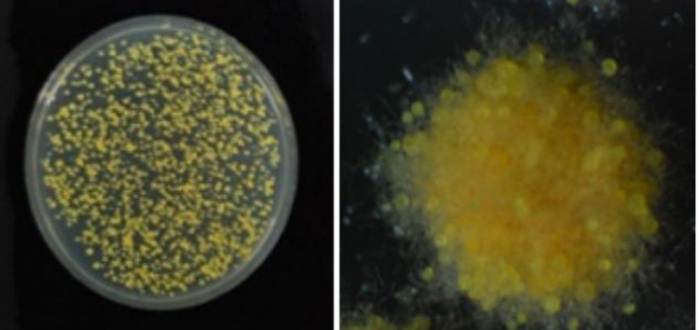

|
| ±ÝÈ±Õ ¹è¾ç Àü ¸ð½ÀÀ̸ç, ¿À¸¥ÂÊÀº ¹è¾ç ÈÄÀÇ ¸ð½À. |
(Àç)Çϵ¿³ìÂ÷¿¬±¸¼Ò´Â Ãֱ٠ƯÇãû¿¡ `Áß±¹ º¹ÀüÂ÷·ÎºÎÅÍ ºÐ¸®µÈ ±ÝȱÕÀÎ À¯·ÎƼ¿ò Å©¸®½ºÅ¸ÅÒ ±ÕÁÖ`¿¡ °üÇÑ Æ¯Ç㸦 Ãâ¿ø(Ãâ¿ø¹øÈ£ Á¦10-2013-0017155È£)Çß´Ù°í 6ÀÏ ¹àÇû´Ù.
¡¡
À̹ø ƯÇã´Â Áö³ÇØ ³ó¸²¼ö»ê½ÄǰºÎ °íºÎ°¡°¡Ä¡ ½Äǰ°³¹ß»ç¾÷ °úÁ¦¿¬±¸·Î ¼±Á¤µÈ `À¯·ÎƼ¿ò(Eurotium) sp.¸¦ Ȱ¿ëÇÑ °íºÎ°¡°¡Ä¡ Golden Flower Tea(±ÝÈÂ÷) °³¹ß` °úÁ¦¸¦ ¿¬±¸ÇÏ´Â °úÁ¤¿¡¼ ¾ò¾î³½ ¼º°ú·Î, Áö³´Þ 18ÀÏ Ãâ¿øÇß´Ù.
¡¡
±ÝȱÕÀ̶õ Áß±¹ÀÇ º¹ÀüÂ÷¤ýº¸ÀÌÂ÷ µî ¹Ì»ý¹° ¹ßÈ¿Â÷¿¡ ³ªÅ¸³ª´Â À¯ÀÍÇÑ ±ÕÀ¸·Î, ³ë¶õ»öÀÇ Á¼½ÒÇüųª ¸ð·¡¾Ëó·³ ºÐÆ÷µÅ ¸¶Ä¡ ³ë¶õ»ö ²ÉÀÌ È°Â¦ ÇÉ °Íó·³ º¸À̸ç ÀÌ ±ÕÀ» ÀÌ¿ëÇØ ¸¸µç Â÷¸¦ ±ÝÈÂ÷¶ó ºÎ¸¥´Ù. Áß±¹¿¡¼± ¹ßÈ¿Â÷ Áß¿¡¼µµ ±ÝȱÕÀÌ ÇÉ Â÷°¡ °í°¡¿¡ ÆÇ¸ÅµÇ´Â µî °íºÎ°¡°¡Ä¡ Â÷·Î ¾Ë·ÁÁ® ÀÖ´Ù.
¡¡
Çϵ¿³ìÂ÷¿¬±¸¼Ò´Â À̹ø ¿¬±¸¸¦ ÅëÇØ ±ÝȱÕÀ» ´ÜÀÏ Å¬·ÐÀ¸·Î ºÐ¸®Çϰí À¯ÀüÀںм®À» ÅëÇØ ±ÝȱÕÀÓÀ» µ¿Á¤(¹àÈû)ÇßÀ¸¸ç, ±¹¸³³ó¾÷°úÇпø ³ó¾÷À¯ÀüÀÚ¿ø¼¾ÅÍ¿¡ ƯÇã¹Ì»ý¹°(KACC93171P)·Î ±âŹÇß´Ù.
¡¡
Çϵ¿³ìÂ÷¿¬±¸¼Ò´Â ƯÇãÃâ¿øÀ» ¹ÙÅÁÀ¸·Î ÇöÀç ±ÝȱÕÀ» Ȱ¿ëÇÑ ¹Ì»ý¹° ¹ßÈ¿Â÷ Á¦Á¶°øÁ¤ ¹× ³ó°¡º¸±Þ¿ë Á¾±ÕÈ¿¡ ´ëÇÑ ¿¬±¸¸¦ ÁøÇàÇϰí ÀÖ´Ù.
¡¡
 |
| °úÁ¦ ¿¬±¸Ã¥ÀÓÀÚÀÎ ±èÁ¾Ã¶ ¹Ú»ç |
°úÁ¦ ¿¬±¸Ã¥ÀÓÀÚÀÎ ±èÁ¾Ã¶ ¹Ú»ç´Â "ÇâÈÄ ±ÝÈÂ÷ Á¦´Ù¹ýÀ» È®¸³ÇØ ³ó°¡ ¹× ±â¾÷ÀÇ ±â¼úÀÌÀüÀ¸·Î Â÷ÀÇ ¼Òºñ È®´ë´Â ¹°·ÐÀ̰í ÇѤýÁß FTA(ÀÚÀ¯¹«¿ªÇùÁ¤)¿¡ ´ëºñÇØ ¹Ì»ý¹° ¹ßÈ¿Â÷ÀÇ °æÀï·ÂÀ» ³ô¿© Áß±¹¿¡ ¿ª¼öÃâÇÒ ¼ö ÀÖ´Â ±â¹ÝÀ» È®¸³ÇϰڴÙ"°í ¹àÇû´Ù. ¡¡
/¿©µÎÈ ±âÀÚ